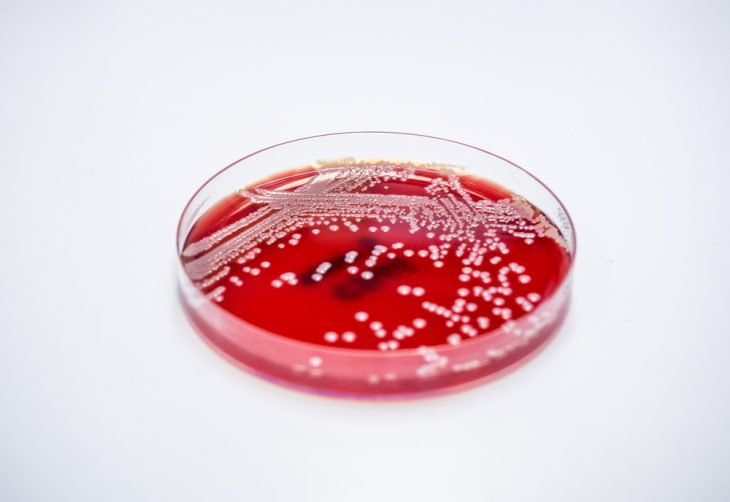
Стафілокок в горлі у дітей і дорослих: причини, симптоми і лікування інфекції

Дещо про стафилококках
Небезпечні бактерії. Стафілокок має можливість проникати через шар епідермісу і викликати запальні і алергічні реакції. Містить у собі фермент, який руйнує клітини шкіри. Стійкий до антибіотиків, швидко звикає до них і перестає реагувати на руйнівні здібності ліки.
Крім того, що наявність золотистого стафілокока в горлі робить його стійким до антибіотиків, він може витримувати високу температуру до 150 градусів. Він не піддається висушування, його не беруть сольові розчини і перекис водню. Часті ячмені і фурункули також свідчать про наявність стафілокока.
Потрапляючи в кров, бактерія може викликати сепсис, тобто зараження крові. У крові цей мікроб виробляє токсини, які провокують різні захворювання. Це пневмонія, менінгіт, мастит, остеомієліт.
При хорошому імунітеті мікроорганізми ніяк себе не проявляють. Вони мешкають у слизових людини: в носі, горлі, на очах, у піхві, кишечнику; але не дають про себе знати. Вони можуть з’явитися тільки на тлі ослабленого організму.
Що це таке і наскільки небезпечно
До бактерій сімейства стафілококів, здатних вражати слизові оболонки в організмі людини, відносяться епідермальний, гемолітичний, і сапрофітний стафілокок. Прогресуючи, бактерії можуть викликати запалення на нових ділянках, поширюючись по організму.
Тим самим вони підсилюють його сприйнятливість до інших бактерій, а також викликають загострення наявних хвороб. При цьому найбільш небезпечним є золотистий стафілокок. На його тлі всі інші «поступаються» за силу впливу, так як він здатний виробляти стійкість до багатьох лікувальних препаратів.
Особливу небезпеку являє собою метицилінрезистентний золотистий стафиллокок: він викликає важко виліковні хвороби у людей.
Симптоми стафілококової інфекції в горлі
Носійність інфекції, як правило, безсимптомний. При ослабленні захисних сил організму золотистий стафілокок у горлі може викликати симптоми гнійної ангіни:
- раптовий підйом температури тіла;
- сильний головний біль;
- слабкість, погіршення апетиту;
- збільшення мигдаликів, в результаті чого може з’явитися дискомфорт при ковтанні їжі, гіперемія слизової і поява гнійного нальоту;
- збільшення регіонарних лімфатичних вузлів.
Прояви золотистого стафілокока в горлі не специфічні, тому підозрювати його починають не відразу. Починають лікувати застуду, ангіну звичними засобами, безсилими проти бактеріальних інфекцій.
Щоб визначити захворювання, необхідно провести лабораторні дослідження, здати мазок з зіву на стафілокок. Направити на посів бактеріальної флори можуть педіатр, терапевт, отоларинголог. Якщо епізоди захворювання повторюються, потрібна консультація інфекціоніста, імунолога. До здачі мазка із зіву потрібно підготуватися:
- Не полоскати горло, рот кілька діб до аналізу, не користуватися спреями, що містять антибіотики.
- Перед дослідженням не чистити зуби. Зранку нічого не їсти і не пити.
Методи діагностики інфекції поділяються на:
- Мікроскопічний, при якому отримані препарати забарвлюють спеціальним чином (за методом Грама). Під мікроскопом видно патогенні коки кулястої форми, пофарбовані синім.
- Культуральний: бактерії «пророщують». Результати такого аналізу готуються кілька днів. В результатах аналізів може бути позначений як конкретний вид виявленої бактерії, так і бути написано staphylococcus spp. Це розшифровується як speciales, що передбачає наявність декількох видів стафілококів.
Потрапляючи в горло, стафілокок починає свою діяльність, приносячи людині багато проблем. До основних симптомів ураження горла стафілококом можна віднести:
- Червоні припухлі мигдалини.
- Слизова горла покривається гнійниками або ж на ній присутній білий наліт.
- При ковтанні людина відчуває больові відчуття.
- Підвищується температура.
- Відчувається м’язова слабкість.
Дані ознаки характерні для проявів стрептококової ангіни. Але різниця при цьому значна. Стафілококова інфекція в горлі, на відміну від стрептококової, погано піддається лікуванню антибіотиками. Також вона може просуватися далі вглиб організму і вражати внутрішні органи, суглоби.

При стафилококке в горлі можуть розвинутися різні захворювання, але найчастіше лікарі діагностують стафілококовий ларингіт, фарингіт або тонзиліт.
· сухість і першіння в горлі;
· хворобливе ковтання;
· гнійні пробки;
· осиплість або повна втрата голосу;
· сухий кашель, через кілька днів змінюється вологим, з рясним виділенням мокротиння;
· підвищення температури тіла до 38,1—38,5 °C (інколи вище).
· підвищена температура тіла (37,5 °C і вище);
· в’язкий слизовий наліт на стінках горла;
· першіння, що викликає сухий кашель;
· набряклість м’яких тканин гортані;
· слабкість, загальне погіршення самопочуття;
· біль у горлі, що посилюється при ковтанні;
· сиплий голос.
· різке підвищення температури (до 39-40 °C);
· біль у горлі, переходить на віскі, м’язи шиї, вуха;
· головний біль, слабкість, запаморочення, сльозотеча;
· скупчення білувато-жовтого нальоту на слизових оболонок гортані, дужках і язичку (легко видаляється);
· освіта гною на мигдалинах;
· гіперемія слизових оболонок мигдалин і горла;
· озноб;
· збільшення лімфовузлів в області шиї;

· сильний біль при ковтанні;
· втрата апетиту.
Якщо патогенний мікроорганізм в ротоглотці став збудником запалення, дізнатися про це можна за низкою ознак.
Але, враховуючи, що стафілококова інфекція в горлі викликає різні захворювання, деякі її симптоми можуть розрізнятися.
Наприклад, при ларингіті в області гортані відчуваються болі, що посилюються при ковтанні. Слизова оболонка органу запалюється, з неї може виділятися гній.
При тонзиліті, запаленні піднебінних мигдалин, яке спричинене стафілококом, спостерігається різке підвищення температури тіла (до 40°с), сильний головний біль і запаморочення, мигдалини швидко переповнюються кров’ю і набрякають, а шийні лімфатичні вузли збільшуються.
На мигдалинах з’являється жовто-білий гнійний наліт, сильна біль в горлі іррадіює в скроню або вухо. Стафілокок в носоглотці викликає нежить і набряк слизової оболонки.
На шкірі носа, щік і навколо рота можуть з’явитися почервоніння, прищики або гнійнички.
Для всіх перерахованих вище захворювань, спровокованих бактерією родини Micrococcaceae, існує кілька загальних ознак, які дозволяють судити про наявність стафілокока в області горла й носоглотки:
- підвищення температури тіла;
- сухість і першіння в горлі (або в носі);
- зміна голосу (осиплість), іноді повна його втрата;
- сухий кашель;
- болю в горлі;
- гортань виглядає почервонілою і набряклою;
- слизовий наліт присутній на глотці або мигдалинах.
Наявність перерахованих вище симптомів у дорослого або дитини є підставою для негайного звернення до лікарів.
Так як мікроб може існувати в організмах багатьох людей, їм варто подбати про зміцнення свого імунітету.
Для профілактики стафілококового запалення потрібно займатися спортом, гуляти на свіжому повітрі, правильно харчуватися, обмеживши вживання солодощів.
Курцям необхідно відмовитися від згубної звички, оскільки вона знижує імунітет.
Щоб уникнути інфекції, викликаної бактерією родини Micrococcaceae, лікарі рекомендують дотримуватися правил особистої гігієни, частіше мити руки з милом. Персоналу медичних установ необхідно працювати в рукавичках і масках.
Щоб стафілокок не викликав запалення, особливу увагу своєму здоров’ю слід приділяти в період поширення простудних захворювань (рання весна і середина осені). В
це час в профілактичних цілях лікарі рекомендують приймати противірусні препарати. При перших ознаках захворювання варто йти в поліклініку.
Якщо в сім’ї стафілокок виявили у однієї людини, іншим теж потрібно обстежитися на його наявність. Дотримуючись нескладні профілактичні заходи, можна захистити себе від руйнівної діяльності патогенного мікроорганізму.
Симптоми початку захворювання, спровокованого стафілококом схожі на розвиток інших бактеріальних або вірусних інфекцій. Тому лікарі часто фіксують остаточний діагноз після отримання результатів клінічних аналізів.
Характерні для зараження золотистим стафілококом наступні симптоми (багато з них проявляються, якщо збудником є стрептокок):
- Швидкий, гострий початок хвороби з високою температурою — до 40оС.
- Почервоніння глотки, мигдаликів. При наявності золотистого стафілокока в горлі помітна виражена набряклість гланд. Біль при ковтанні, через деякий час больові відчуття виникають при вдиху, потім стають постійними.
- Через кілька годин після початку недуги можуть бути помітні білястий наліт або гнійні освіти на мигдалинах.
- Інтоксикація організму: нудота, ломота в м’язах, невиражена головний біль.

Симптоми початку захворювання, спровокованого стафілококом схожі на розвиток інших бактеріальних або вірусних інфекцій
Якщо у вас фарингіт
- Набрякає слизова горла, починається утворення лусочок, але частіше — надлишкової кількості слизу.
- Біль у горлі, першіння, що провокують сухий кашель.
- В’язкі слизові виділення помітні при візуальному огляді.
- Загальне нездужання плюс підвищення температури.
Для ларингіту, якщо його збудником є золотистий стафілокок або стрептокок, є характерними багато симптоми з перерахованих, плюс осиплість, зміна тембру голосу. Часто хвороба ускладнюється трахеїт.
| Назва препарату | Форма випуску | Принцип дії |
|---|---|---|
| «Стафілококовий анатоксин» | ампули для ін’єкцій | стимулює вироблення специфічного імунітету проти більшості штамів стафілококів та їх токсинів |
| «Стафілококовий антифагин» | ампули для ін’єкцій | підвищує антимікробний імунітет, що прискорює процес знищення хвороботворних мікробів в організмі |
| «Стафилофаг» | розчин для промивання та зрошення ротоглотки | вимиває більшість бактерій із слизових оболонок та підвищує місцевий імунітет |
| «Сектафаг» | сироватка для ін’єкцій | перешкоджає розмноженню стафілококів, стрептококів і інших грампозитивних мікробів |
| «Интести-бактеріофаг» | розчин для перорального прийому | знищує бактерії у слизових оболонках ШЛУНКОВО-кишкового тракту і органів дихання, перешкоджає розвитку дисбактеріозу |

Більшість антистафілококових ліків, які мають побічну дію, тому їх використовують переважно для лікування дорослих.
До складу ліків входять токсичні компоненти, які створюють навантаження на печінку і нирки, тому їх не рекомендується використовувати особам, які страждають печінковою або нирковою недостатністю.
Як вилікувати золотистого стафілокока? Золотистий стафілокок – найгрізніший представник кокова бактерій, розвиток якого тягне за собою тяжкі системні ускладнення. Він виділяє токсини, які можуть накопичуватися в нирках, серці, суглобах та інших органах, викликаючи важкі захворювання.
Для знищення в організмі золотистого стафілокока може використовуватися наступна схема лікування:
- закопування «Стафілококового бактеріофага» в ніс протягом 7-10 днів по 3-4 мл в кожну ніздрю;
- прийом «Бронхо-мунала» по 1 капсулі на день натщесерце протягом місяця;
- впорскування по 2 дози «ІРС-19» в кожну ніздрю двічі на добу протягом 10 днів.
Приблизно через місяць після проходження терапії потрібно зробити контрольний посів на мікрофлору. При відсутності золотистого стафілокока в організмі пацієнту призначають прийом імуностимулюючих засобів. Якщо ж носійство бактерій зберігається, бажано провести вакцинацію анатоксином.
Причини захворювання, як воно передається
На жаль, причини захворювання занадто банальні, тобто людині досить важко убезпечити себе від інфікування стафілококом. Перша – це зниження імунітету, коли незначна присутність бактерій в організмі саме по собі переростає в загострення.
- Безпосередній контакт немитих рук (або предметів) зі слизовою оболонкою (наприклад, звичка гризти нігті, або коли діти беруть в рот немиті предмети, облизують пальці) – простіше кажучи, це недотримання правил гігієни.
- Перебування в одному приміщенні з носієм інфекції (вдихання повітря, в якому містяться бактерії, що потрапили туди шляхом выдыхания, кашлю або чхання носія);
- Немиті продукти, погано вимитий посуд, неякісний догляд за одягом та речами.
- Зараження дитини при пологах (навколоплідними водами)
Як заражаються стафілококом
Часто підхопити стафілококову інфекцію можна в лікарняних закладах, пологових будинках та поліклініках. Було вже сказано, що лікування його важке, а якщо не лікувати, то це може призвести до плачевних наслідків. Варто знати причини зараження цією інфекцією, щоб надалі убезпечити себе.
Отже, шляхи зараження стафілококом:
- Повітряно-крапельний: при чханні або кашлі.
- Контактний: при користуванні предметами особистої гігієни або посудом хворого, при тісному контакті з інфікованою людиною.
- Вживання продуктів, заражених стафілококом. Наприклад, це може бути молоко хворої корови, яйця, м’ясо, кондитерські вироби.
- Через грудне вигодовування.
- Часто цим захворювань схильні діти з-за постійного облизування пальчиків.
- Джерелами проникнення стафілококу можуть стати такі захворювання, як фарингіт, карієс, бронхіт, ларингіт.
Діагностика та лікування стафілокока в горлі
До того як лікувати стафілокок в горлі, крім зовнішнього огляду, необхідно здати аналізи. Зараз для постановки діагнозу використовуються серологічний та мікробіологічний методи. Мікробіологічний аналіз проводиться так: у пацієнта з горла, матеріал поміщають в живильне середовище, що має здатність до фарбування. Через добу аналізують результати посіву. Якщо пігмент жовтого кольору, значить, у людини звичайний стафілокок в зіві, і лікування не потрібно. У такому випадку потрібно шукати істинну , — це може бути або інше захворювання.
При наявності стафілокока в горлі симптоми проявляються по-іншому: бактерії, потрапивши в живильне середовище, утворюють колонії діаметром до 4 мм, що мають опуклу форму і помаранчевий, білий або жовтий колір. Якщо немає часу чекати, поки бакпосів дасть результати, виявити хворобу може за допомогою коагулазного тесту.

Серологічний метод полягає в тому, що на мікроби впливає стафілококовий бактеріофаг. Їх існує кілька груп, і кожна впливає тільки на певні види патогенних мікроорганізмів.
Є допустима норма вмісту стафілококів в організмі. Вона виражається в мікроскопічних числах, які ні про що не скажуть звичайній людині. Але пацієнт повинен знати, що є різниця між стафілококом і стафілококової інфекцією.
У першому випадку небезпеки немає, у другому — є, і дуже серйозна. Починати лікування потрібно негайно, бо поява інфекції свідчить про слабкому імунітеті, і це означає, що організм не впорається з хворобою власними силами.
Щоб діагностувати стафілококову інфекцію в горлі, слід провести деякі аналізи. Здається посів з ротоглотки на виявлення бактерій. Після того як стафілокок був виявлений, проводиться наступний аналіз на виявлення його чутливості до ряду антибіотиків.
Як було вже описано, лікування золотистого стафілокока в горлі не передбачає застосування антибіотиків. Варто звернути увагу на зміцнення імунної системи. У цих цілях призначається вітамінотерапія, антистафілококовий плазма та імуномодулюючі препарати.

У момент лікування протипоказані будь-які фізіотерапевтичні процедури, це пов’язано з тим, що вони спрямовані на заходи прогрівання, що категорично заборонено при стафілококової інфекції, так як запалення перекинеться далі й збільшиться.
З медикаментозних препаратів призначаються:
- Напівсинтетичні і захисні пеніциліни.
- Аміноглікозиди.
- Тетрациклін.
- Офлоксацин.
- Кліндаміцин.
- Препарати, що підвищують імунну систему, імуноглобуліни.
- Антисептики для полоскання.
- Вітаміни.
Особливо в дитячому віці застосовується стафілококовий бактеріофаг. Він є вірусом бактерій. Цей препарат діє на певну групу мікробів, не пошкоджуючи інших. Є нормалізатором мікрофлори в області скупчення мікробів. Не має побічних дій.
Часто стафілококова інфекція протікає з симптомами ангіни, тому і лікування прописується відповідна. В першу чергу призначається постільний режим, рясне пиття і полоскання горла. Якщо виникає необхідність, то застосовуються, особливо в дитячому віці, жарознижувальні препарати і протизапальні засоби. Стафілокок в горлі у дитини лікується тими ж способами, що і у дорослих.
У разі якщо при здачі аналізів у здорової людини була виявлена стафілококова паличка, то лікування антибіотиками та іншими препаратами не проводиться. Курс лікувальної терапії призначають лише працівникам медичних установ і людям, пов’язаним з громадським харчуванням.
Якщо жінка планує вагітність, то їй теж необхідно здати аналіз на присутність збудника в крові. Незайвим буде, якщо і передбачуваний майбутній батько дитини теж пройде цю процедуру.
Хоча симптоми стафілокока в горлі свідчать про його наявність в організмі, у медичному закладі лікарі, крім зовнішнього огляду пацієнта, призначають йому кілька аналізів.

Якщо мікроорганізм призвела до пневмонії, у людей беруть зразок крові. Перевіряють у лабораторії матеріал на гемоліз (руйнування) еритроцитів, визначаючи по реакції крові вид бактерії стафілокока.
Якщо гемоліз відбувається, то в горлі присутній золотистий вид мікроорганізму, а якщо ні, то там живе епідермальна бактерія.
Щоб дізнатися про наявність в ротоглотці мікроорганізмів, в першу чергу досліджують зразки збудника, взяті з бульбашок, гнійників, жовто-білого нальоту.
Мазок на стафілокок з горла не тільки виявляє представників мікрофлори, що живуть на слизовій оболонці, але і дозволяє дізнатися кількість бактерій, що знаходяться там.
Норма мікроорганізмів становить 10 у 4 ступені КУО/мл середовища, де СЯК — це колонієутворюючих одиниць. Якщо цей показник вище, бактерій міститься на слизових більше чим потрібно, тому стафілокок в горлі запускає легко запальний процес.

Досліджуючи мазки, завжди становлять антибиотикограмму, тобто визначають чутливість мікроорганізмів до антимікробних засобів, щоб призначити надалі правильні препарати для лікування.
Золотистий стафілокок у носі та горлі, а також стрептокок, можуть стати причиною ГРВІ, фарингітів, тонзилітів, ринітів, інших захворювань даного ряду. Потрапляючи на слизові ззовні активний золотистий (або іншого роду) стафілокок, пригнічує здорову мікрофлору, впроваджується в епітелій носоглотки людини — так виникає запальний процес.
Подібні бактерії заражають організм повітряно-краплинним або контактним шляхом. Вдихнувши порцію патогенних мікроорганізмів, отримавши «порцію» коків при використанні загальних предметів гігієни, іграшок або з’ївши заражені страви, можна стати жертвою збудника захворювань.
Лікування золотистого стафілокока в горлі важко. Ця бактерія схильна мутацій і часто виявляється резистентної до різних груп антибіотиків. Тому лікар у проблемних випадках призначає клінічні аналізи, серед яких значиться мазок з носових ходів або зіву для бакпосіву і перевірки реакції мікроорганізму на різні групи ліків.

Золотистий стафілокок схильний до мутацій і часто виявляється резистентним до різних груп антибіотиків
Стафілококовий або стрептококовий варіант інфекції — досить небезпечний мікроорганізм. Він може вижити в екстремальних умовах, буває аеробним і анаеробним. Отрута, який виділяє золотистий стафілокок — ентеротоксин — потрапляє в кров, викликає сильну інтоксикацію.
Стафілокок в горлі у дитини частіше вражає мигдалини. Катаральна форма недуги без своєчасного лікування швидко переходить у гнійні форми. В ексудаті, скопившемся в лакунах і гнійних пробках, розташованих в лімфоїдних тканинах гланд під епітелієм, створюється сприятливе середовище для розвитку бактерій.
Ослаблений імунітет не здатний подолати активність бактерій, стрептокок, стафілокок або пригнічують здорову флору, фагоцити не справляються з атакою. Захворювання може бути спровоковано суб’єктивними факторами, що викликали збій у роботі систем організму. Це:
- Стреси, постійний емоційний дискомфорт.
- Нераціональне харчування: відсутність необхідних вітамінів і мінералів.
- Неконтрольований прийом ліків, зловживання антибіотиками.
- Дисбактеріоз, який порушує обмін речовин.
- Хронічні, системні захворювання, що роблять організм беззахисним перед активізацією стафілокока.
Стафілокок може роками існувати в некритичних кількостях на слизових оболонках ЛОР-органів і проявитися тільки у сприятливий для його розвитку момент.
Щоб точно встановити наявність у горлі золотистого стафілокока, зовнішнього огляду недостатньо, тому беруть мазок з носа і зіву. Наявні в мазку бактерії поміщаються в живильне для них середовище. Їм потрібно не більше 1 доби, щоб почати утворювати колонії (це мікробіологічний аналіз).
Цей метод можна скоротити до 4-х годин з допомогою коагулазного тесту. Але якщо його результат негативний, то аналіз, все ж, продовжується до покладених 24 годин. Також є другий метод, але він менш точний – серологічний.
Він полягає в тому, що мікроби піддаються дії бактеріофагів. Недоліком методу є їх здатність впливати лише на певні патогенні мікроорганізми, внаслідок чого точність цього способу скорочена до 60 % і використовується вкрай рідко.
Симптоми інфекції не специфічні, для верифікації діагнозу необхідно провести лабораторні дослідження – посів бактеріальної флори з ротоглотки. При виявленні в біологічному матеріалі золотистого стафілокока також проводиться визначення його чутливості до антибактеріальних препаратів.
Для лікування стафілококової інфекції призначається антибактеріальна терапія, лікар застосовує препарати, тільки враховуючи результати аналізу. Самолікування в даному випадку неприпустимо. З-за високої стійкості цих патогенних бактерій до антибіотиків, багато з них просто виявляться неефективними відносно золотистого стафілокока, але при цьому можуть завдати шкоди кишкової мікрофлори.
При неефективності або неможливості проведення антибактеріальної терапії пацієнтам призначається стафілококовий бактеріофаг, який, по суті, є вірусом бактерій. Його переваги полягають у тому, що він впливає тільки на певні патогенні мікроорганізми, не ушкоджуючи при цьому нормальну мікрофлору, не має протипоказань і побічних ефектів.
Симптоматичне лікування при розвитку гнійного процесу у ротоглотці в результаті впливу золотистого стафілокока таке ж, як при ангіні. Хворим рекомендується постільний режим, рясне тепле питво, при необхідності застосовуються жарознижуючі і знеболюючі препарати. Кілька разів на день полоскати горло теплим відваром ромашки або шавлії.
Народні засоби лікування
· м’якоть абрикоса (приймати у вигляді пюре вранці і ввечері);
· плоди чорної смородини (їсти натщесерце в свіжому вигляді);
· ванни з яблучним оцтом (50 г на ванну);
· настоянка прополісу (використовувати для полоскання)
· настій із суміші лікарських трав (купити в аптеці і приймати по інструкції).
Народні методи грають важливу роль в лікуванні горла при стафілококової інфекції. Рекомендується щодня чорну смородину і абрикоси – вони допомагають у боротьбі з цим мікробом.
Ось ще деякі способи перемогти інфекцію:
- Відвар ехінацеї і лопуха. Змішати в рівних пропорціях коріння цих рослин, після чого взяти 2 чайні ложки суміші залити 400 гр гарячої води. Поставити на повільний вогонь і трохи поварити. Приймати відвар слід 3 рази в день по 1 склянці.
- Настій шипшини. Дві жмені плодів насипати в термос і залити окропом, залишити, не чіпаючи, на 10 годин. Приймати потрібно по півсклянки 2 рази на день.
- Відвари для полоскання. Слід змішати в однаковій кількості шишки хмелю, запашну м’яту, кипрей, корінь аїру і насіння кропу. Взяти 1 столову ложку засоби і залити 1 літром окропу, злити суміш в термос і залишити на 7-8 годин. Після цього робити полоскання і приймати по 100 мл
Чим ще лікувати золотистий стафілокок в горлі?
Лікування даного захворювання має полягати в комплексному підході. Тобто, вживання призначених лікарем ліків (антибіотиків) супроводжується роботою над підвищенням імунітету, а також лікуванням народними засобами (полоскання, трави).
Якщо аналіз показав таку кількість стафілокока в горлі, як 10*3 КОЕ, хвороба не має гострого перебігу, а досліджуваний – не дитина або літня (ослаблений, болючий) людина, то в більшості випадків починати лікування антибіотиками не варто.
Досить буде опрацювати свій імунітет і звернути увагу на здоровий спосіб життя (фізкультура, здорове харчування, свіже повітря). Якщо ж аналіз показав 10*4 КОЕ – це сигнал до застосування ліків, які повинні бути доповнені промиванням горла 4 рази на день розчином спиртової настоянки календули (1 ч. л. на склянку води) або хлорофіліпту.
Хлорофиллипту у боротьбі з мікробами слід приділити особливу увагу, оскільки він показаний для лікування антибіотикостійких стафілококів. Також можна вживати відвар із звіробою і календули (за 30 хвилин до їжі), заварюючи їх за рецептом.
Стафілокок часто резистентен по відношенню до простих антибіотиків пеніцилінової групи. Тому лікарі призначають Амоксицилін, а його вдосконалену версію — Амоксиклав з клавуланової кислоти.
Така добавка дозволить захистити діюча речовина від передчасного розпаду під впливом ферментів, що продукуються бактеріями. Рекомендуються також диспергуються таблетки Флемоклав: з них можна приготувати солодкувату суспензію з цитрусовим ароматом — таким чином легко вирішити проблему «чим лікувати інфекцію у дитини без конфліктів і примх».

Макроліди — Азитроміцин, Сумамед — допоможуть алергікам або тим, у кого є звикання до пеніциліну. Вплив ліків пролонговано — 5-7 днів діюча речовина ще знаходиться в тканинах, і «працює»: вбудовується в клітини бактерій і руйнує їх.
Линкозамиды вважаються сильнодіючими антибіотиками. Кліндаміцин активний проти золотистого стафілокока (він згубний і для такої інфекції, як стрептокок). Можливий прийом таких ліків для дітей від 8 років.
Отоларингологи також виписують препарати з ряду цефалоспоринів або аміноглікозидів. Антибактеріальна терапія є обов’язковою при захворюваннях даної категорії.
Доповненням служить симптоматичне лікування. Прискорять одужання:
- Пастилки, таблетки для розсмоктування, спреї. Вони дезінфікують і злегка знеболюють глотку, сприяють загибель патогенної мікрофлори. Ісла, Анзибел, Лизобакт, Інгаліпт, Ангилекс, Гівалекс застосовуються дорослими пацієнтами, які не мають протипоказань. А початковий вік прийому можна прочитати в інструкції. Але саму точну консультацію дасть лікар. Нео-ангін — непоганий анальгетик. А Граммицин і Биопарокс містять у складі антибіотик, який місцево впливає на вогнище запалення.
- Рекомендовані полоскання розчинами Фурациліну, Тантум Верде, Ротокана.
- Антигістамінні препарати пом’якшують реакцію організму на антибіотик і знімають набряклість.
- Нестероїдні протизапальні засоби — на основі панадола, німесуліду — знизять жар, нададуть протизапальну дію.
Також підтримати організм допомагає імунотерапія. Популярні препарати на основі інтерферону. Імудон підвищує захисні властивості організму. Також вироблення природних ферментів, що забезпечують освіту натуральних антитіл, допоможуть препарати:
- Лікопід, надає потужний ефект при відновленні після ЛОР-захворювань.
- Аміксин стимулює вироблення власного інтерферону.
При лікуванні стафілокока ефективний Хлорофіліпт у всіх формах: таблетки для розсмоктування, спиртовому спреї, масляному розчині для обробки слизової.

Розрідженню і відходженню слизу, в якій знаходиться патогенна мікрофлора, сприяють інгаляції
Для полоскання або інгаляцій використовують відвари ромашки, шавлії (з розрахунку столову ложку аптечного або висушеної сировини на склянку води). Ефірна олія чайного дерева також є речовиною згубним для золотистого стафілокока.
Такий розчин допоможе організму боротися з бактеріями резистентними до звичайних антисептиків. В теплу воду додають по 2-3 краплі олії на 300 мл Хорошим дезинфікуючим і протизапальну речовиною вважається масло обліпихи.
Полоскати горло потрібно розчином температури тіла. Періодичність процедур — від години до двох. Подібний метод дозволяє видалити з глотки виділення з хвороботворними мікроорганізмами, очистити епітелій, зменшити активність патогенної флори.
Помітивши перші ознаки захворювання потрібно звертатися до лікаря, щоб вчасно уточнити діагноз і приступити до ефективного лікування.
Інфекція, розвиваючись, здатна спричинити за собою серйозні ускладнення, і в цьому криється головна небезпека. Бактерії продукують небезпечні токсини, які накопичуються в м’язових тканинах, нирках, легенях, печінці та селезінці.
При наявності мікробів у горлі лікування повинно бути своєчасним, інакше може початися зараження крові, здатне привести до летального результату.
· Протягом тижня закапувати в ніс краплі «Стафілококовий бактеріофаг», по 4 краплі в кожну ніздрю;
· 2 рази на день, протягом 10 днів, впорскувати подвійну дозу ліків «ІРС-19» в кожну ніздрю;
· Протягом 30 днів пити по 1 капсулі препарату «Бронхо-мунал» (вранці, до їди).
Рекомендована тривалість терапевтичного курсу, якою зазвичай вистачає, щоб позбутися від інфекції — 1 місяць. Потім необхідно зробити контрольний бакпосев, щоб переконатися, що лікування золотистого стафілокока в горлі дало результати.
Якщо носійство патогенних мікроорганізмів не виявлено, можна почати приймати імуностимулятори. При наявності мікробів у кількості, що перевищує норму, слід зробити ін’єкцію стафілококового анатоксину.

Висновок: швидко і ефективно вилікувати золотистий стафілокок можливо тільки при взаємодії з лікарем та виконання усіх рекомендацій. Застосовувати рецепти народної медицини не забороняється, але вони повинні виступати не заміною повноцінної терапії, а доповненням до неї.
Таке захворювання як стафілококова ангіна вимагає до початку лікування здачі аналізів на чутливість до антибіотиків. Тоді лікування буде результативним. Лікар повинен підібрати антибактеріальні засоби, які впораються в конкретному випадку.
Антибіотики
Для лікування стафілокока в горлі використовуються антибіотики нового покоління. До них відносяться інгібітор-захищені і напівсинтетичні пеніциліни. Наприклад, амоксицилін, діюча речовина ряду препаратів, таких як «Амоксиклав».
При лікуванні дітей застосовують розчинні, що диспергуються форми («Флемоклав солютаб»). У цих пігулках амоксицилін поєднується з клавуланової кислотою, щоб перемогти стійкість бактерій до антибіотика.
Інші антибіотики, що застосовуються для лікування стафілокока: аміноглікозиди («Неоміцин»), цефалоспорини («Зиннат», «Цефтріаксон»), макроліди («Азитроміцин»). Який антибіотик зможе вилікувати хворобу, може визначити тільки лікар.
Доктор призначить дозування ліків: вона залежить від віку та ваги пацієнта. Тривалість прийому може бути різною, одне незмінно: пити антибіотики потрібно не менше 5 днів, навіть якщо вам стало легше раніше. Переривати процес прийому не можна.
Поширені засоби для полоскання горла при стафилококке, що володіють антисептичним ефектом: «Фурацилін», «Хлоргексидин», «Диоксидин» і «Хлорофіліпт». Особливо популярний останній препарат. Він випускається в таблетках, у вигляді розчину на масляній або спиртовій основі.
Засіб знижує резистентність стафілокока до антибіотиків, збагачує тканини киснем, працює як антисептик і антибактеріальну ліки. «Хлорофіліпт» вживають, щоб доповнити дію антибіотиків на бактерії, посилити його. Як готувати і застосовувати розчин для полоскання:
- На 100 грамів теплої води взяти чайну ложку 1% спиртового розчину препарату.
- Полоскати 4 рази (кожні 3 години) протягом доби після їди. Триває процедура не менше п’яти хвилин. Розчин використати протягом однієї процедури, не залишати на потім – він втратить антисептичні властивості.
- Не можна ковтати ліки. Не їсти і не пити півгодини після процедури.
Бактерія швидко виробляє стійкість до антимікробних препаратів. Якщо з’ясовується їх неефективність, лікар призначає бактеріофаг. Він діє тільки на патогенний мікроб, не пошкоджуючи інші. Препарат приймають всередину, використовують для зрошень, аплікацій, полоскання, закапування.
Поширена причина, по якій відбувається інфікування організму стафілококом – знижений імунітет. Для профілактики і терапії інфекції, викликаної бактеріями, використовують анатоксини. Фактично, це щеплення, покликана виробити імунітет.
Препарат вводиться підшкірно, потрапляє в кров, організм виробляє антитіла. Стафілококовий анатоксин вводять тільки дорослим, під лопатку, по 0,5 мл, через день. Курс – 5 уколів. Через місяць повторюють.
Народні засоби
Застосування відварів за народними рецептами полегшує перебіг захворювання, прискорює одужання. Ось кілька способів лікування стафілокока натуральними засобами:
- Свіжі фрукти і ягоди. Щодня рекомендується вживати в їжу 100 г чорної смородини і 500 г абрикос.
- Відвар лопуха та ехінацеї. Подрібнити коріння рослин, 2 чайних ложки заварити чотирма склянками окропу. Довести на малому вогні до кипіння, пити по склянці тричі на день.
- Збір на травах. Все береться по 1 столовій ложці: череда, чебрець, багно, деревій, березові бруньки. Залити сировину 2 склянками окропу, настояти 2 години, пити по півсклянки 4 рази за добу.
Профілактичні заходи
Так як стафілокок може передаватися повітряно-крапельним і побутовим шляхом і в основному він проявляється на тлі зниженого імунітету, важливо стежити за гігієною тіла, вести здоровий спосіб життя і зміцнювати імунітет.
Якщо виникає необхідність прийому антибіотиків, то призначати їх повинен тільки лікар. Контролюйте якість їжі, не їжте зіпсовані та прострочені продукти. Особливо це стосується молочних виробів, м’яса, яєць. Зберігайте швидкопсувні продукти в холодильнику.
Якщо у вас маленька дитина, то варто знати, що більше всього схильні до цього захворювання саме маленькі діти, з тієї причини, що дитяча імунна система до кінця не сформована. І ще малюки так люблять пробувати на смак, а це прямий шлях заразитися цією інфекцією.
Зміцнюйте в першу чергу дитячий організм, підбирайте правильну і потрібну їжу, загартовуйте дитини, якщо виникає необхідність, давайте малюкові вітаміни. В сучасний час була розроблена вакцина проти стафілококового анатоксину, вона робиться маленьким дітям, по можливості варто її зробити.
Наслідки
Серед усіх патогенних мікроорганізмів найбільш небезпечним вважається золотистий стафілокок. Він не тільки викликає запалення органів ротоглотки, але і здатний привести до різних ускладнень при відсутності лікування.
Пов’язано це з тим, що він може подорожувати по всьому організму людини. Найстрашнішим наслідком цієї бактерії вважається сепсис (зараження крові), його підсумок — смерть потерпілого.
Ускладненням золотистого стафілокока є ендокардит (ураження тканин, що вистилають серце зсередини).
Смертність при цьому захворюванні доходить до 60% всіх клінічних випадків. Патогенний мікроорганізм викликає менінгіт (запалення оболонок мозку).
Серед усіх різноманітних бактерій, що знаходяться в організмі людини, наслідки часто проявляються саме від інфікування стафілококом. Вони досить різноманітні, але піддаються угруповання:
- Харчові отруєння – найбільш часті. Вони викликані вживанням неякісної, простроченої, необробленої або немитої їжі.
- Поверхневі прояви – запалення слизових оболонок, ураження шкіри.
- Ураження внутрішніх органів, які викликають їх хвороби (стафілококовий цистит, уретрит, пієлонефрит) або ускладнюють вже наявні хронічні або невиявлені захворювання.
- Найнебезпечніші наслідки – зараження крові, абцесс легенів (гнійне запалення), міокардит, токсичний шок.
Щоб уникнути таких складних ситуацій необхідно вчасно виявити наявність інфекції, а також, займатися профілактикою захворювань.
Способи зараження
Попадання цієї бактерії на слизову оболонку глотки може відбутися при контакті з хворою людиною або носієм патогенної флори, інфекція передається повітряно-крапельним шляхом, при вживанні в їжу продуктів, заражених стафілококом.
Дуже часто золотистий стафілокок у горлі виявляється у дітей, оскільки при активному дослідженні навколишнього світу вони тягнуть в рот багато предметів, на поверхні яких можуть накопичуватися будь-які бактерії.

Потрапляючи в горло людини, золотистий стафілокок зазвичай не викликає ніяких захворювань і ніяк себе не проявляє, але це зовсім не означає, що він нешкідливий. При ослабленні імунної захисту можуть з’явитися симптоми бактеріальної інфекції у глотці (стафілококова ангіна).
- Зміцнення імунітету;
- прийом будь-яких антибактеріальних препаратів тільки за призначенням лікаря;
- санація вогнищ хронічної інфекції в ротовій порожнині та верхніх дихальних шляхах;
- дотримання правил особистої гігієни (миття рук перед їжею і т. д.);
- контроль якості та свіжості вживаної їжі, дотримання умов зберігання продуктів.
Здорова людина стає носієм стафілококової інфекції в горлі тоді, коли вдихає повітря з розташованими в ньому бактеріями. Якщо це відбувається на тлі (або після) тривалого лікування антибіотиками, ослаблення імунної системи, гормональних порушень, вірусної інфекції або ендокринного захворювання, розвивається запалення.
В горлі утворюється гнійний наліт, м’які тканини мигдалин починають , може розвинутися тонзиліт і інші захворювання. Якщо лікар діагностує стафілокок горла, лікування потрібно проводити не тільки антибіотиками, але і іншими таблетками. Також потрібно враховувати, що мікроб може бути стійкий до препаратів, які пацієнт приймав раніше.
· Контактний. Нехтування правилами гігієни призводить до того, що бактерії-стрептококи та стафілококи потрапляють в гортань з предметів побуту, дитячих іграшок, посуду. Наприклад, потримавши за дверну ручку, на якій є бактерії, і піднісши руки до рота, людина ризикує заразитися.
· Повітряно-крапельний. Перебуваючи в одному приміщенні з хворим, здорова людина вдихає повітря, в якому є бактерії, і через деякий час виявляє симптоми стафілокока в горлі.
Стафілокок ауреус в горлі може з’явитися навіть після того, як людина вдихне повітря з деякою кількістю мікроорганізмів. Доведено, що мікроб може тривалий час перебувати в повітрі, залишаючись життєздатним.
Профілактика інфікування золотистим стафілококом
Існує кілька шляхів потрапляння патогенних бактерій в організм людини:
- Повітряно-крапельний. Відбувається при вдиханні здоровою людиною повітря, зараженого шкідливими стафілококами. У повітря вони виділяються носієм внаслідок його дихання, кашлю та чхання.
- Контактно-побутовий. Мікроорганізми потрапляють на слизові оболонки і шкіру при рукостисканнях людей, при користуванні загальними предметами (іграшками, фломастерами та олівцями в дитячому садку і школі, рушниками та ін). Часто стафілокок в горлі дитини з’являється при недотриманні ним правил гігієни (контакт брудних рук з ротовою порожниною).
- Аліментарний механізм передачі. Патогенний мікроб потрапляє в ротову порожнину разом з обсемененной бактеріями їжею. На продукти мікроорганізми переходять з брудних рук хворих кухарів та працівників продовольчої сфери. Стафілокок може потрапити в організм дитини, коли його годує грудьми інфікована мати.
- Внутрішньоутробний шлях зараження. Якщо у вагітної жінки шкідливі бактерії мешкають в родових шляхах, то вони можуть інфікувати малюка при пологах.
- Повітряно-пиловий спосіб. Зустрічається рідко, в тих випадках, коли стафілококи довго живуть в пилу, а з неї з вдихуваним повітрям потрапляють в носоглотку людини.
- Артіфіціальним спосіб. На недостатньо стерильних медичних інструментах, приладах, за допомогою яких проводять оперативне втручання або діагностують захворювання внутрішніх органів методами бронхоскопії, ендоскопії та ін., теж нерідко присутні стафілококи.
Таким чином, бактерія родини Micrococcaceae потрапляє в людський організм по-різному, але при виявленні всіх можливих вогнищ інфекції з нею легше буде впоратися.
Профілактика зараження стафілококом досить проста, і посильна кожному:
- Дотримання особистої гігієни і гігієни приготування їжі.
- Раціональне харчування.
- Вологе прибирання приміщень та їх провітрювання.
- Регулярні фізичні навантаження, прогулянки на свіжому повітрі.
- Дотримання режиму сну і неспання.
Принципи лікування

Якими аптечними засобами потрібно лікувати золотистий стафілокок в горлі? Золотистий стафілокок – один з найбільш небезпечних штамів бактерій, який володіє стійкістю до більшості антибіотиків. Він виділяє особливі ферменти, які нейтралізують дію протимікробних засобів.
Основними цілями терапії стафілококової інфекції є:
- пригнічення активності збудників інфекції;
- відновлення цілісності уражених слизових;
- підвищення загального і місцевого імунітету.
Неускладнені форми ЛОР-захворювань можна вилікувати з допомогою місцевих антибіотиків, але якщо стафілококова інфекція поширилася за межі горла і вразила нижні дихальні шляхи, в схему терапії включають системні антибіотики і сильнодіючі антистафилококковые препарати.
На етапі вирішення запальних реакцій хворому може бути призначено курс фізіотерапевтичних процедур. Проходження УФ-терапії дозволяє нормалізувати окислювально-відновні процеси в тканинах, підвищити місцевий імунітет і знищити патогенну мікрофлору в дихальних шляхах.
Знищити патогенні мікроорганізми можна лише шляхом комплексного впливу, так як стрептокок і стафілококи можуть бути утворені різними штамами, кожен з яких володіє стійкістю до певної групи антибіотиків. Крім того, колонії стафілокока в горлі у дорослих і дітей виділяють речовини, що нейтралізують ефективність деяких препаратів. Для боротьби з інфекцією застосовують антистафилококковые медикаменти: анатоксини, імуноглобуліни, бактеріофаги.
· зміцнюється місцевий і неспецифічний імунітет;
· швидко гояться уражені слизові оболонки і м’які тканини;
· пригнічується активність хвороботворних мікроорганізмів — збудників інфекції.
Місцеві антибіотики (таблетки, ін’єкції) допомагають пацієнтам, у яких є стрептокок на мигдалинах або стафілококова інфекція в горлі. Якщо вражені не тільки тканини та слизові оболонки гортані, але й дихальні шляхи (позалегеневі і внутрилегочные розгалуження бронхів, трахеї, бронхіоли), проводять терапію сильнодіючими противостафилококовыми медикаментами та системними антибіотиками. Корисно робити полоскання препаратами Мірамістин, Фурацилін.
· УФО горла;
· УФО носа;
· тубус-кварц;
· електрофорез;
· гелій-неоновий лазер;
· струми УВЧ.
Антимікробні препарати системної дії випускаються у вигляді спреїв, ін’єкційних розчинів, сиропів, таблеток, суспензій, капсул. Ефективно знищують золотистий стафілокок в горлі у дитини препарати стійкі до бета-лактамазою та пеніцилінази — ферментам, синтезуються патогенними бактеріями.
Рослинні адаптогени
Рослинні адаптогени (фитоадаптогены) – ліки, які підвищують опірність організму хвороботворних вірусів, грибків, бактерій, найпростіших і т. д. До їх складу входять мікроелементи і вітаміни, які стимулюють неспецифічний імунітет, за рахунок чого знижується ймовірність розвитку інфекційних захворювань.
Яких результатів чекати від прийому адаптогенів? Стафілококи виділяють токсичні речовини, які призводять до отруєння організму і появи спільних ознак інтоксикації – відсутність апетиту, хронічна втома, апатія, швидка стомлюваність і т. д.
Регулярний прийом рослинних адаптогенів не тільки покращує якість життя хворого, але і перешкоджає загострення бактеріального запалення в респіраторному тракті. До числа найбільш дієвих фітопрепаратів відносять:
- лимонник;
- настоянку ехінацеї;
- обліпиху;
- рожеву радіолу;
- аралію.
Не можна приймати адаптогени пацієнтам, які страждають гіпертензією, так як більшість з них сприяють підвищенню артеріального тиску.
Перед використанням фитосредств вагітними жінками і дітьми бажано проконсультуватися з лікарем. Надлишок біологічно активних речовин в організмі може призвести до побічних ефектів, появи кропив’янки, безсоння, сильного свербежу та набряку слизових.

Препарати, що містять рослинні компоненти, відносять до групи фитоадаптогенов. Їх дія спрямована на підвищення опірності організму до різних патогенних організмів: найпростіших, вірусів, мікробів, грибків.
У складі таких препаратів зазвичай містяться біологічно активні речовини, мікроелементи і вітаміни. В результаті застосування рослинних адаптогенів знижується ризик захворіти, а у тих, хто вже страждає від розвиненого інфекційного захворювання, поліпшується загальний стан.
· знижується стомлюваність;
· поліпшується апетит;
· приходить в норму самопочуття;
· зникає біль у горлі;
· проходить набряк мигдаликів;
· зменшується або повністю зникає гіперемія.

Якщо до цього були інші ознаки інтоксикації стафілококом, вони також зменшуються. Рослинні препарати корисні тим, що сприяють швидкому одужанню, запобігають загострення хвороби і знижують ризик рецидиву в подальшому.
· аралія;
· родіола рожева;
· лимонник;
· обліпиха;
· ехінацея.
Всі препарати випускаються у вигляді настоянок і екстрактів. Що краще приймати від золотистого стафілокока, підкаже лікуючий лікар.

При вагітності екстракти і настої приймати не рекомендується. В крайньому випадку, необхідно попередньо проконсультуватися з гінекологом. Подібні засоби підвищують тиск, при цьому можливі несприятливі наслідки як для плоду, так і для самої жінчині.
Антистафилококковые препарати
Лікувати золотистий стафілокок в горлі у дитини, і у дорослого необхідно з використанням медикаментів, що зміцнюють захисні сили організму.
· Тактивін;
· Рибомуніл;
· Полудан;
· ІРС-19.
Лікуватися необхідно не тільки до зникнення симптомів запалення, але і протягом місяця після того, як настане одужання. Такі препарати слід приймати хворим у рамках терапії при стафилококке горлі, так і всім, хто страждає вторинним імунодефіцитом. Імуностимулятори значно знижують ризик розвитку інфекційних захворювань.
Відео про особливості лікування золотистого стафілокока в горлі у дітей
Враховуючи, що ослаблений організм гірше чинить опір інфекції, при однакових обставинах стафілокок в горлі у дитини або вагітної жінчині з’явиться з більшою ймовірністю, чим у інших категорій пацієнтів.
Проте лікувати дітей і майбутніх мам складніше із-за великої кількості протипоказань і обмежень. Вибираючи, чим лікувати стафілокок, лікар повинен враховувати й індивідуальні особливості кожної людини.
Методи боротьби з інфекцією в горлі у дітей підбирає педіатр, а схема лікування вагітної жінки підбирається лікарем-інфекціоністом, при цьому може знадобитися участь гінеколога, який веде вагітність.
Отримуючи на руки результати аналізу на мікрофлору, багато хто бачать у них слово «стафілокок». Варто турбуватися, якщо при цьому симптоми інфекції відсутні? Передасться чи бактерія від мами-носія дитині, і чи обов’язково він захворіє після цього?
Ці питання хвилюють батьків. Нерідко дорослі, отримавши позитивний аналіз на стафілокок, починають лікуватися незрозуміло від чого. У пропонованому відео доктор Комаровський розповість про бактерії-збудники інфекції, про стафілококової ангіні у дітей, і лікуванні малюків.
Як передається
Стафілокок – Школа доктора Комаровського


